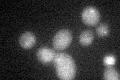
YOR258W

View description
Member of the third branch of the histidine triad (HIT) superfamily of nucleotide-binding proteins; similar to Aprataxin, a Hint related protein that is mutated in individuals with ataxia with oculomotor apraxia
Localization:
Intensity:
Fold change:
Significance:
-
C’ GFP library in SD

below threshold18.77 -
N' NOP1pr-GFP in SD

cytosol87.3482 -
N' TEF2pr-mCherry in SD

missing0 -
N' NATIVEpr-GFP in SD

missing0 -
N' TEF2pr-VC and Cyto-VN in SD

#N/A0 -
C’ GFP library in SD+DTT
cytosol19.461.03No -
C’ GFP library in SD+H2O2

cytosol15.70.83No -
C’ GFP library in Starvation Media

cytosol18.740.99No -
C’ GFP library on the background of Pup2-DaMP

below threshold -
C’ GFP library on the background of CCT mutant

below threshold17.34680.923592No
